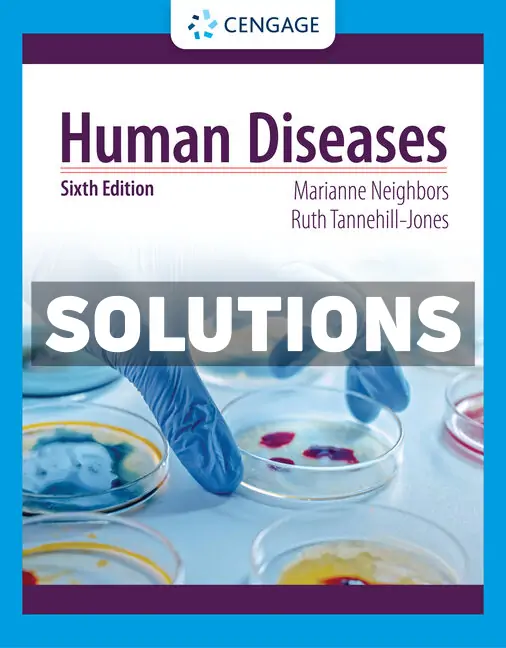

Human Diseases 6th Edition Neighbor Solutions Manual
$65.00 Original price was: $65.00.$31.00Current price is: $31.00.
Unlock the comprehensive understanding of human diseases with the “Human Diseases 6th Edition Neighbor Solutions Manual.” This detailed resource is designed to accompany the Human Diseases textbook, offering step-by-step solutions to all the complex problems presented in the book.
Perfect for students and educators alike, this solutions manual provides clear and concise explanations to enhance your learning experience. Whether you’re preparing for exams or seeking to deepen your knowledge, this guide is an indispensable tool for mastering the material.
Instantly downloadable and easy to navigate, our solutions manual is your key to academic success. Authentically sourced from the publisher, it includes complete solutions for all chapters, ensuring a thorough understanding of all topics.
Why Choose the Human Diseases 6th Edition Neighbor Solutions Manual?
This solutions manual is more than just answers; it’s an educational journey that equips you with the insights needed to excel in your studies. Embrace an optimal learning experience with our expertly crafted solutions guide.
– Comprehensive, step-by-step solutions for all textbook problems
– Accurate and reliable content directly from the publisher
– Instant download for immediate access to all chapters
– Enhances learning and prepares students thoroughly for exams
– Essential resource for students and educators in the domain of human diseases and healthcare
Make the Human Diseases 6th Edition Neighbor Solutions Manual your go-to companion for mastering the intricacies of human diseases today.

Reviews
There are no reviews yet.